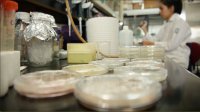

León, Gto., a 4 de octubre de 2021.- Priorizando actividades académicas que requieren uso de laboratorios, la División de Ciencias e Ingenierías (DCI) del Campus León desarrolla sus actividades presenciales con una participación aproximada al 30 por ciento de su matrícula, en un esquema gradual, voluntario y con apego a los protocolos sanitarios que mantiene la Universidad de Guanajuato (UG) durante el semestre agosto-diciembre 2021.
Así lo informó en entrevista, el Dr. David Yves Ghislain Delepine, Director de la División, quien señaló que el cumplimiento de los protocolos es indispensable para que las y los investigadores puedan recibir a sus estudiantes en el laboratorio, tanto para las UDA híbridas que se llevan en licenciaturas, como para la realización de investigaciones a nivel posgrado, pues dijo, la generación de conocimiento para la división es fundamental, ya que se caracteriza por la generación de patentes, productos de investigación, artículos científicos; así como por la formación de recursos humanos de alto nivel.
Actualmente, la matrícula de la División de Ciencias e Ingenierías en el Campus León de la Universidad de Guanajuato (UG) asciende a 832 estudiantes; 702 estudiantes en licenciaturas como: Física, Ingeniería Biomédica, Ingeniería Física y la Licenciatura en Ingeniería Química Sustentable, mientras que 130 estudiantes pertenecen a posgrados del Doctorado y Maestría en Física, y de la Maestría en Ciencias Aplicadas.
El Dr. Ghislain Delepine afirmó que se mantiene el compromiso de ofertar cursos de remediación para las y los estudiantes que de manera voluntaria quieran cubrir las actividades prácticas de laboratorio que tuvieron que realizar de forma virtual por la pandemia, lo que esperan suceda a finales de año y durante el próximo semestre.
Con la finalidad de minimizar los riesgos de contagios, la Universidad de Guanajuato en conjunto con sus Campus y Divisiones continúan implementando acciones para proteger a su comunidad, al tiempo que se mantiene un llamado a la corresponsabilidad.
Entre estas acciones, destaca el transporte universitario gratuito para estudiantes, personal académico y administrativo, que permite reducir la exposición al virus SARS-CoV-2 durante los traslados en el transporte público. El Campus León reactivó el servicio con traslados matutinos y vespertinos, el cual para la DCI comprende un circuito que va de la estación de transferencia -San Jerónimo- a la sede ubicada en Campestre, con paradas de ascenso y descenso intermedias.
Para acceder al servicio la comunidad de la UG debe presentar credencial vigente o formato de inscripción al semestre en curso. Cabe señalar que el servicio también se encuentra disponible para la Sede San Carlos.
Otra de las acciones a las que se refirió el también académico, es el tamizaje aleatorio con pruebas de saliva, con la técnica PCR "Pool testing", realizado por el Laboratorio Universitario de Diagnóstico Molecular de la Universidad de Guanajuato (LUDIMUG).
Además, la DCI mantiene a disposición de sus estudiantes el centro de cómputo, con la intención de facilitarles una conexión inmediata para tomar las clases virtuales, sobre todo, al salir de alguna UDA presencial y no contar con tiempo suficiente para el traslado. Únicamente -por medidas sanitarias- se les solicita llevar sus audífonos.
Para finalizar, el Dr. David Yves Ghislain Delepine hizo un exhorto a la comunidad estudiantil de la DCI a mantenerse en constante comunicación con las autoridades y docentes, y agregó que, en caso de tener propuestas para realizar las actividades académicas durante la pandemia, las puedan plantear.
A su vez externó la invitación a que revisen de manera frecuente sus correos institucionales, pues a través de este medio se les hace llegar información relevante, como las actualizaciones en las rutas del trasporte universitario.
Galería fotográica